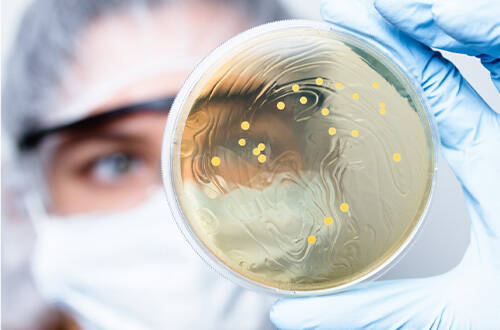
Микробиологическая лаборатория «на отлично»: как организовать и чем наполнить

-
Зерновые культуры
- Процессы, необходимые для исследования зерновых культур
-
Показатели качества зерна
- Сорность, зараженность вредителями
- Натура
- Стекловидность
-
Влажность
- Сушильные шкафы для зерна
- Анализаторы влажности зерна
- Влагомеры зерна
-
ИК-анализаторы для контроля уровня влажности в зерне
- Инфракрасные анализаторы цельного зерна AgriCheck для контроля уровня влажности
- ИК-анализатор зерна, кормов и пищевых продуктов SpectraStar XT Unity Scientific
- Портативный ИК-анализатор цельного зерна IAS 3120, Intelligent Analysis Service для контроля уровня влажности
- ИК анализатор QuikCheck
- Потоковые анализаторы зерна для производственных линий
-
Белок
-
ИК-анализаторы
- Портативный ИК-анализатор цельного зерна IAS 3120, Intelligent Analysis Service для контроля уровня белка
- Инфракрасные анализаторы цельного зерна AgriCheck для контроля уровня белка
- Потоковые анализаторы для производственных линий
- ИК-анализатор зерна, кормов и пищевых продуктов SpectraStar XT Unity Scientific
- Определение белка в зерне методом Кьельдаля
- Определение белка методом Дюма
-
ИК-анализаторы
- Маслянистость
- Клетчатка
- Зольность
- Клейковина
- Число падения
- Микотоксины
- ГМО в зерне
- Сажка
- Радионуклиды
- Токсичные элементы
- Пестициды
-
Масличные культуры
- Процессы
-
Показатели качества масличных культур
- Сорная и масличная примесь, зараженность
- Натура
-
Влажность
- Сушильные шкафы
- Анализаторы влажности
- Влагомеры зерна
-
ИК-анализаторы
- Инфракрасные анализаторы цельного зерна AgriCheck для контроля уровня влажности в масличных культурах
- Портативный ИК-анализатор цельного зерна IAS 3120, Intelligent Analysis Service для контроля уровня влажности в масличных культурах
- ИК анализатор QuikCheck
- Потоковые анализаторы для производственных линий
- ИК-анализатор зерна, кормов и пищевых продуктов SpectraStar XT Unity Scientific
-
Белок
-
ИК-анализаторы
- Инфракрасные анализаторы цельного зерна AgriCheck
- Портативный ИК-анализатор цельного зерна IAS 3120, Intelligent Analysis Service для контроля уровня белка в масличных культурах
- Потоковые анализаторы для производственных линий
- ИК-анализатор зерна, кормов и пищевых продуктов SpectraStar XT Unity Scientific
- Определение белка методом Кьельдаля
- Определение белка методом Дюма
-
ИК-анализаторы
-
Жир (масличность)
- Определение жира методом импульсной ЯМР-спектроскопии
- Определение жира методом экстракции
-
ИК-анализаторы
- Инфракрасные анализаторы цельного зерна AgriCheck для контроля уровня жира в масличных культурах
- Портативный ИК-анализатор цельного зерна IAS 3120, Intelligent Analysis Service для контроля уровня жира в масличных культурах
- ИК-анализатор зерна, кормов и пищевых продуктов SpectraStar XT Unity Scientific
- Кислотное число (кислотность)
- Олеиновая кислота
- ГМО
- Микотоксины
- Радионуклиды
- Токсичные элементы
- Пестициды
- Глюкозинолаты
-
Комбикорм
- Процессы
-
Показатели качества комбикормов
- Влажность
- Белок
- Жир (масличность)
- Клетчатка
- Крахмал
- Зольность
- Фосфор
- Кислотность, кальций и содержание соли (NaCl)
- Активность уреазы
- Общая токсичность кормов
- Хрупкость гранул
- Прочность гранул
- Радионуклиды
- Пестициды
- Аминокислотный анализ комбикормов
- Микотоксины
- Витамины
- Тяжелые металлы
-
Масла и жиры
- Процессы, необходимые для исследования масел и жиров
-
Показатели качества растительного масла
- Жир (шрот, жмых)
- Белок (шрот, жмых)
- Клетчатка (шрот, жмых)
- Кислотное число
- Перекисное число
- Анизидиновое число
- Олеиновая кислота
- Фосфорсодержащие вещества (фосфолипиды)
- Цветность
- Йодное число
- Влажность
- Вязкость масла
- Температура вспышки
- Жирнокислотный состав
- Окислительная стабильность
- Контроль гигиены поверхностей и жидкостей
-
Семена
- Процессы
- Показатели качества семян
-
Почва
-
Процессы, необходимые для исследования почвы
- Пробоотбор
- Взвешивание
- Сушка
- Измельчение
- Выделение фракции
- Подготовка воды
- Приготовление вытяжки
- Мойка и дезинфекция
-
Показатели качества почвы
- Кислотность вытяжки почвы
- Общее солесодержание и электропроводность
- Активность ионов
- Азот (нитратная и аммонийная формы)
- Фосфор
- Азот щелочногидролизуемый (по Корнфилду)
- Азот
- Калий
- Кальций и магний (обменные)
- Гранулометрический состав
- Углерод
- Органическое вещество (гумус) в почве
- Микроскопическое исследование почвы
- Элементный состав и загрязнение металлами
- Стойкие органические загрязнители
- Радионуклиды
- Нефтепродукты
- Экспресс-анализ почвы в поле
-
Процессы, необходимые для исследования почвы
-
Молоко
- Процессы, необходимые для исследования молока
-
Показатели качества молока
- Массовая доля сухих веществ в молоке
- Плотность молока
- Кислотность молока
- Чистота молока
- Точка замерзания молока
- Массовая доля жира в молоке
- Массовая доля белка в молоке
- Содержание лактозы
- Микробиологические показатели
- Количество соматических клеток
- Наличие веществ, продлевающих сроки хранения молока
- Остатки антибиотиков
- Содержание мочевины
- Содержание афлатоксина М1
- Токсичные элементы (тяжелые металлы)
- Содержание пестицидов
- Фальсификаты
- Определение эффективности пастеризации
- Определение уровня термообработки
- Термоустойчивость молока
-
Молочные продукты
- Процессы, необходимые для исследования молочных продуктов
-
Показатели качества молочных продуктов
- Аллергены
- Жир
- Белок
- Чистота
- Насыпная плотность
- Размеры кристаллов сахара
- Зола
- Вязкость
- Кухонная соль
- Кислотность
- Свободные жирные кислоты
- Влага и сухие вещества
- Перекисное число жира
- Лактоза
- Плотность
- Сахар
- Бензойная и сорбиновая кислоты
- Натамицин (Е325)
- Жирно-кислотный состав
- Щелочная фосфатаза
- Стериновая фракция и триглицериды
-
Мука
- Процессы, необходимые для исследования муки
-
Показатели качества муки
- Зараженность вредителями, загрязненность и металлопримеси
- Крупность
- Влажность
- Белок
- Клейковина
- Белизна (цвет муки)
- Зольность
- Число падения
- Кислотность
- Микотоксины
- Радионуклиды
- Токсичные элементы
- Пестициды
- Мед
- Мясо и мясные продукты
- Микробиология
-
Безалкогольные напитки
-
Основные показатели качества
- Титрованная и общая кислотность
- рН (активная кислотность)
- Сухие вещества
- Свойства напитков
- Сахара и подсластители
- Гидроксиметилфурфурол
- Витамины
- Микотоксины
- Органические вещества в напитках
- Комплексные показатели питьевой и минеральной воды
- Определение герметичности закупоривания
- Экспресс-анализ на производстве
- Устойчивость
- Мутность
- Пектиновые вещества
- Спирт
- Концентрация СО2
- Цвет
-
Основные показатели качества